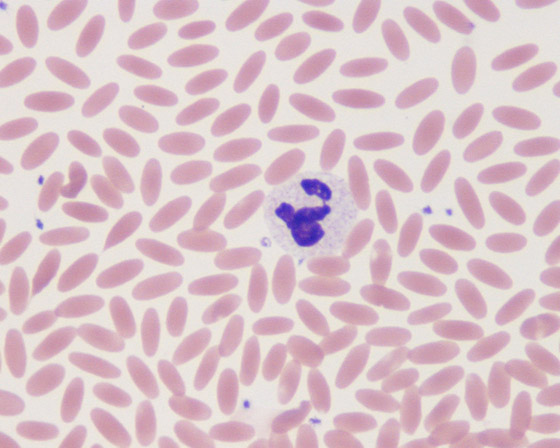
أمل يلوح من الإبل.. دم حيوان اللاما علاج محتمل لوباء كورونا صورة رقم 11

أمل يلوح من الإبل.. دم حيوان اللاما علاج محتمل لوباء كورونا
كغريق يتعلّق بقشة، مازال العلم يسعى جاهداً لإيجاد مخرج ينهي مأساة تفشي فيروس كورونا المستجد حول العالم والمستمرة منذ أشهر. والجديد اليوم ومضة أمل أتت من بريطانيا، فقد أعلن باحثون أن الأجسام المضادة المستخلصة من دم حيوان اللاما أو الإبل يمكن هندستها وراثيا كي تستهدف الوباء، وتكون علاجا مستقبليا، حيث تنتج اللاما، وكذلك الإبل، أجساماً مضادة متناهية الصغر، تسمى الأجسام النانوية، والتي تعد بالغة الضآلة مقارنة بتلك التي تنتجها أجهزة المناعة البشرية.

تحييد وحظر المُستجد
ووفقا لما نشرته صحيفة بريطانية، توصلت التجارب إلى أن هذه الأجسام المضادة الطبيعية يمكن تكييفها لتحييد الفيروس المُستجد عن طريق الربط بإحكام على "بروتين السنبلة" المحيط بما يحظر دخوله إلى الخلايا البشرية. ولا يزال البحث في مرحلة مبكرة للغاية، إلا أنه شهد تحولاً سريعاً مؤخراً، حيث يكثف الأكاديميون في معهد روزاليند فرانكلين في جامعة أكسفورد البريطانية من إجراءات عملية بحثية تستغرق عادةً ما يقرب من عام كي يتم إنجازها خلال 12 أسبوعًا فقط. فيما يرجح الباحثون أن الأجسام النانوية المشتقة من اللاما يمكن فقط تطويرها في نهاية المطاف كعلاج لحالات الإصابة الشديدة بعدوى كورونا المُستجد.
كمصل النقاهة
من جهته، أفاد البروفيسور جيمس نايسميث، مدير معهد روزاليند فرانكلين وأستاذ علم الأحياء البنيوي في جامعة أكسفورد، الذي يقود الدراسة البحثية قائلاً: "إن هذه الأجسام النانوية يمكن استخدامها بطريقة مماثلة لمصل النقاهة، ولوقف تطور الفيروس بقوة في أجسام المرضى في مراحل متأخرة من مرض كوفيد-19، تمكن الدراسة من دمج أحد الأجسام النانوية مع جسم مضاد بشري وإظهار أن التركيبة كانت أقوى من أي منهما منفردًا". فيما تعد تلك التركيبات مفيدة بشكل خاص حيث يجب على الفيروس تغيير أشياء متعددة في نفس الوقت للمناورة والهروب من الأجسام المضادة لاقتحام الخلايا البشرية؛ وهو أمر صعب للغاية بالنسبة للفيروس في هذه الحالة.

يخادع كالذئب
يغزو فيروس كورونا المُستجد الخلايا البشرية عن طريق الإغلاق على مستقبلات على سطح الخلايا البشرية تسمى ACE2، والتي يطلق عليها "مفتاح الدخول" لجسم الإنسان. كما يستخدم الوباء قدرته على إخفاء بروتيناته الفيروسية كوسيلة لخداع جهاز المناعة في الجسم، مما أكسبه وصف "الذئب في ملابس الأغنام".
بهذا السبب، ركز علماء جامعة أكسفورد على منع الفيروس من التسلل عبر مستقبلات ACE2 عن طريق حجبه جسدياً، كما استخلص العلماء أجسامًا نانوية من دم لاما، تُسمى فيفي، في جامعة ريدينغ وقاموا بتعديلها وراثيا في المختبر لاستهداف التفاعل بين طفرات الفيروس، المغلفة في السكريات المعروفة باسم جليكان، ومستقبلات ACE2. ونجحت التجارب في إنتاج جسمين مضادين نانويين، تم تسميتهما H11-H4 وH11-D4، وهما متشابهان جداً في الشكل والبنية مع بعضهما بعضا.

كما تم استخدام الجسمين المضادين النانويين معاً لتحييد فيروس كورونا حي، وأظهر H11-H4 فاعلية عالية بشكل خاص، عن طريق الإغلاق إلى 3 مواقع مميزة على ارتفاع سنبلة بروتين المُستجد، حيث ارتبط الجسمان النانويان بشكل آمن بالطفرة الفيروسية ومنع الارتباط بين ارتفاع الفيروس والخلية البشرية المستهدفة.
تصوير متطور بالغة الدقة
إلى ذلك، تمكن الباحثون من معرفة مدى فعالية الجسمين المضادين على الفيروس باستخدام التصوير المتقدم مع الأشعة السينية والإلكترونات، مما وفر نظرة مفصلة متناهية الدقة على التفاعل بين الفيروس والخلايا. وأظهر التصوير المتطور أن الأجسام النانوية ترتبط بـ"سنبلة البروتين" بطريقة جديدة ومختلفة عن الأجسام المضادة الأخرى المكتشفة بالفعل. في السياق، أفاد البروفيسور ديفيد ستيوارت من جامعة أكسفورد، بأن المجاهر الإلكترونية أكدت أن الأجسام النانوية يمكن أن ترتبط بالطفرة الفيروسية، وتغطي الأجزاء التي يستخدمها الفيروس لدخول الخلايا البشرية.

علاج محتمل
ونشرت النتائج، على الرغم من أنها مبكرة، بعد فحصها من قبل أكاديميين آخرين عبر مراجعة الأقران، حيث قال البروفيسور راي أوينز من جامعة أكسفورد، والذي يقود برنامج الجسم النانوي في معهد روزاليند فرانكلين: "نأمل أن نتمكن من دفع هذا الإنجاز إلى تجارب ما قبل السريرية".
فيما أفاد باحثون آخرون بأن الأجسام النانوية يمكن أن تقدم الأمل كعلاج لمرض كوفيد-19، حيث يُظهر المرضى المصابون بحالات متأخرة تحسنا ملموسا بعد حقنهم بمصل من الأفراد المتعافين، والذي يحتوي على أجسام مضادة بشرية ضد الفيروس. وتُعرف هذه العملية بالتحصين السلبي وقد تم استخدامها لأكثر من 100 عام، إلا أن التعمق لمعرفة ماهية الأجسام المضادة الدقيقة، التي تساعد في علاج البشر، يعد أمراً صعباً للغاية. إلى ذلك، يقول الباحثون إن المنتج المعتمد على المختبر الذي يمكن صنعه عند الطلب له مزايا كبيرة ويمكن استخدامه في وقت مبكر في المرض حيث من المرجح أن يكون أكثر فعالية.

حيوان اللاما قد يوفر علاجا للوباء
فبينما لا تفعل فيفي، أنثى اللاما، شيئا سوى مضغ العشب والسير على الحشائش في مراعي ريدنغ، قدم جهاز مناعتها نموذجا لعلاج متقدم لفيروس كورونا. واستخدم علماء من معهد روزاليند فرانكلين بالمملكة المتحدة الأجسام المضادة من جسم فيفي في تطوير علاج معزز للمناعة. ومن المتوقع أن يدخل "خليط الأجسام المضادة"، الذي طُور باستخدام خلايا من جسم حيوان اللاما، مرحلة التجارب السريرية خلال أشهر قليلة. ونشرت تفاصيل هذا البحث في مجلة "ناتشر ستراكشر آند مولكيولار بيولجي" المتخصصة.
وتتضمن هذه التطورات الجديدة، على صعيد تطوير لقاح مضاد للوباء في بريطانيا، عمليات "هندسة بيولوجية" تخضع لها الأجسام المضادة لحيوان اللاما، التي تعتبر صغيرة نسبيا وذات بنية أقل تعقيدا مقارنة بالأجسام المضادة في الدم البشري. ويُعد الحجم الصغير والبنية البسيطة من العوامل التي تمكن العلماء من إعادة تصميمها معمليا.

فك شفرة الفيروس
وصف جيمس نايسميث، مدير معهد روزاليند فرانكلين للأبحاث ورئيس الفريق البحثي الذي يعمل على هذا المشروع، هذا الأسلوب بأنه أشبه بصنع نسخة من مفتاح فيروس كورونا. وقال نايسميث: "باستخدام الأجسام المضادة للاما، لن يكون لدينا مفتاح يتناسب تماما مع فيروس كورونا - سوف يدخل المفتاح في المكان المخصص لكنه لن يكمل دورته". وأضاف: "لذلك سوف نأخذ هذا المفتاح ونستخدم البيولوجيا الجزيئية لصقل أجزاء منه حتى نجعل منه مفتاحا مناسبا" لفك شفرة الوباء.
والأجسام المضادة هي جزء من الجهاز المناعي التكيفي، فهي جزيئات تتحور استجابة لأي فيروس أو بكتيريا تهاجم الجسم. وتابع رئيس الفريق البحثي المطور للقاح المحتمل: "لذا إذا طالتك العدوى مرة ثانية، يبدأ جسمك في البحث (عن جزيئات الفيروس) باستخدام الأجسام المضادة التي تقتله". ويدعم هذا النوع من العلاج الجهاز المناعي للمريض بأجسام مضادة متكيفة بالفعل مع الفيروس.

وتتوافر أدلة على أن الدم الغني بالأجسام المضادة، المأخوذ من المتعافين من الوباء، قد يستخدم في العلاج من فيروس كورونا. لكن الجديد في استخدام الأجسام المضادة الخاصة بحيوان اللاما هو أن العلماء سوف يتمكنون من إنتاج أجسام مضادة لفيروس كورونا تحديدا عندما يريدون استخدامها دون الحاجة إلى دم مرضى سابقين.
وأشار نايسميث إلى أن الأجسام المضادة لحيوان اللاما تُعرف أيضا بأنها "أجسام مضادة متناهية الصغر". وقال أيضًا: "في المعمل، يمكننا أن نحصل على أجسام مضادة قادرة على الفتك بالفيروس النشط بقوة - أفضل من أي شيء آخر شاهدناه من قبل." وأضاف: "إنها تقتل الفيروس في المزرعة المعملية بكفاءة مذهلة".

وتقوم هذه الأجسام المضادة بربط ما يُعرف بـ"البروتين المسماري"، المسؤول عن دخول فيروس كورونا خلايا الجسم، أو منعه من من دخول كبسولة الفيروس والإبقاء عليه خارجها. ويؤدي إبطال مفعول هذا البروتين إلى فشل الفيروس في الدخول إلى خلايا الجسم.
أدوية من اللاما
قال نايسميث: "ما نقوم به في المعمل هو بالتأكيد ما تقوم به أجهزة المناعة في الجسم". وأضاف: "يمكننا أن ننتهي من ذلك بسرعة، لذلك إذا تغير الفيروس فجأة أو ظهر لدينا فيروس آخر، سوف نتمكن من إنتاج أجسام مضادة باستخدام الهندسة الوراثية في المعمل". ويستهدف الفريق البحثي اختبار العلاج المحتمل على الحيوانات هذا الصيف، متوقعين البدء في التجارب السريرية على البشر في وقت لاحق من هذا العام.

للتواصل معنا
للتواصل معنا 